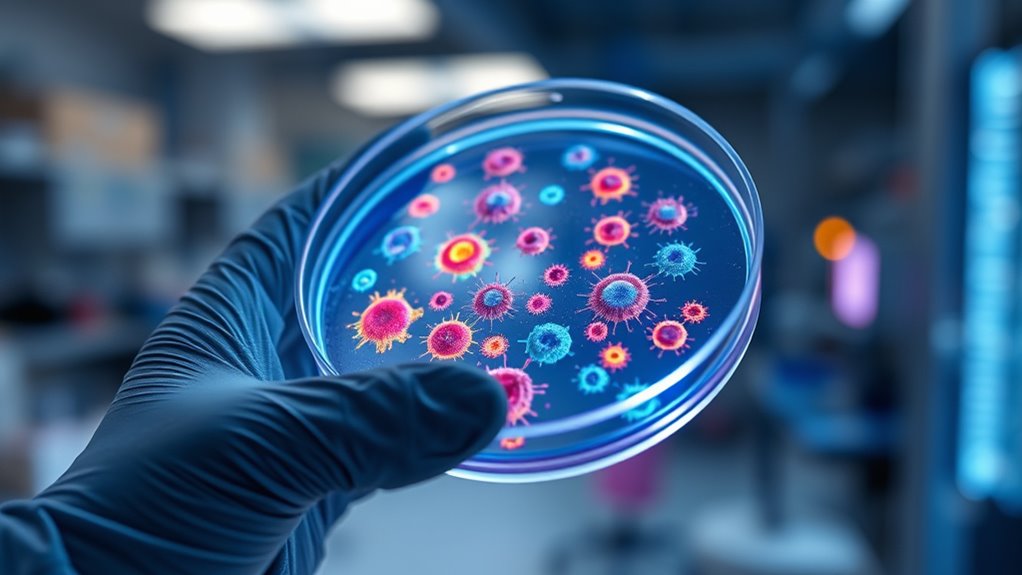
targeted personalized cancer therapies

In precision oncology, targeted cancer treatments focus on attacking specific genetic mutations and molecular pathways unique to your tumor. By discovering biomarkers, doctors can select therapies tailored to your cancer’s genetic profile, increasing effectiveness while reducing side effects. Resistance can develop, so ongoing research aims to overcome these challenges with new and combination therapies. If you want to understand how these innovative strategies work together to improve outcomes, the next details will provide more clarity.
Key Takeaways
- Precision oncology employs biomarker discovery to identify specific genetic mutations in tumors for tailored treatments.
- Targeted therapies focus on interfering with cancer-specific pathways, enhancing effectiveness and reducing side effects.
- Advanced genomic sequencing detects mutations that guide personalized drug selection and treatment strategies.
- Overcoming resistance mechanisms, like secondary mutations, is essential for durable and effective targeted cancer therapies.
- Combining targeted treatments with immunotherapy and developing next-generation drugs address resistance and improve outcomes.
Have you ever wondered how modern medicine is changing the fight against cancer? One of the most exciting developments is the rise of targeted cancer treatments, which focus on attacking specific molecules or genetic mutations that drive tumor growth. This approach relies on biomarker discovery, a process that identifies unique biological indicators associated with a patient’s cancer. By pinpointing these biomarkers, your healthcare team can select therapies tailored precisely to your cancer’s genetic profile, increasing the likelihood of effective treatment while reducing side effects compared to traditional chemotherapy.
Biomarker discovery isn’t just about finding what makes your cancer unique; it also helps uncover resistance mechanisms. Resistance mechanisms are the ways cancer cells adapt to evade treatment, often leading to relapse or treatment failure. As your doctors learn more about these mechanisms, they can adjust strategies or develop combination therapies that block or bypass resistance. This ongoing research makes targeted treatments more durable and effective over time, giving you a better chance at long-term remission.
Understanding resistance mechanisms helps tailor treatments and improve long-term cancer outcomes.
The process begins with advanced genomic sequencing of your tumor, where scientists analyze its DNA to find mutations or alterations that serve as biomarkers. Once identified, these biomarkers guide the selection of targeted drugs that interfere with specific pathways your cancer relies on. For example, if your tumor exhibits a particular genetic mutation, your doctor might prescribe a drug designed to inhibit the activity of that mutated gene. This precision minimizes damage to healthy cells and often results in faster recovery and fewer side effects.
However, cancer’s ability to develop resistance remains a challenge. Resistance mechanisms can include secondary mutations, activation of alternative pathways, or increased drug efflux from the cells. Researchers are continuously studying these adaptations, aiming to develop next-generation therapies that anticipate and counteract resistance. Combining targeted treatments with other modalities, like immunotherapy, is also a promising strategy to stay ahead of resistance and improve outcomes.

Reese's ColoTest, FIT Immunochemical Fecal Occult Blood Test Kit at Home, 1 Ct, Easy to Use Colon Health Screening, Detects Hidden Blood in Stool, 1-Minute Results, 98.8% Accurate
What is ColoTest? ColoTest is an at-home stool test kit that allows you to test for blood in…
As an affiliate, we earn on qualifying purchases.
As an affiliate, we earn on qualifying purchases.
Frequently Asked Questions
How Do Targeted Therapies Differ From Traditional Chemotherapy?
Targeted therapies differ from traditional chemotherapy because they specifically attack cancer cells, sparing healthy ones. You benefit from fewer side effects and can often use combination therapy to improve effectiveness. However, drug resistance can develop over time, making the treatment less effective. Unlike chemotherapy, which affects all rapidly dividing cells, targeted therapies focus on particular molecules or pathways involved in cancer growth, offering a more personalized approach.
What Genetic Markers Are Most Commonly Used in Precision Oncology?
You mostly rely on genetic mutations and biomarker testing to guide treatment decisions. Common markers include EGFR, HER2, ALK, and PD-L1, which help identify specific targets for therapy. You undergo biomarker testing to detect these genetic mutations, enabling personalized treatments that are more effective and have fewer side effects. This approach guarantees your therapy is tailored to your cancer’s unique genetic profile, improving your chances of successful outcomes.
Are Targeted Treatments Effective for All Cancer Types?
You might think targeted treatments work for all cancers, but the truth is more complex. Their effectiveness varies widely, often hinging on biomarker discovery and how tumors develop treatment resistance. While some cancers respond remarkably well, others resist or relapse quickly. The ongoing challenge is identifying reliable biomarkers to personalize therapy, making targeted treatments more universally effective. So, success isn’t guaranteed—yet. The future hinges on unraveling these intricate cancer mechanisms.
What Are the Potential Side Effects of Targeted Cancer Therapies?
You might experience side effects like drug resistance, where cancer cells adapt and become less responsive, or immune reactions, such as inflammation or allergic responses. Common issues include fatigue, skin rashes, or gastrointestinal problems. While targeted therapies are generally well-tolerated, you should report any unusual symptoms to your doctor promptly. Understanding these potential side effects helps you manage your treatment better and stay vigilant for signs requiring medical attention.
How Accessible Are Personalized Treatments Across Different Healthcare Systems?
You might wonder if personalized treatments are within your reach. Access varies widely due to healthcare disparities and insurance coverage gaps, leaving some patients waiting while others receive cutting-edge care. In many systems, high costs and limited availability create barriers, making it uncertain whether everyone can benefit equally. So, while advancements exist, the reality is that accessibility remains uneven, and you could face significant hurdles depending on where you live and your insurance.

KiHealth – Diabetes Risk Test – Test for Early Detection Insights and Glucose Regulation – Simplified Test Kit
EARLY INSIGHT INTO DIABETES RISK – The KiHealth Diabetes Risk Test offers a unique at-home approach to evaluating…
As an affiliate, we earn on qualifying purchases.
As an affiliate, we earn on qualifying purchases.
Conclusion
You might wonder if targeted cancer treatments truly change the game. The evidence suggests they do, offering more precise and effective options with fewer side effects. As research advances, it’s possible that one day, cancer could become a manageable condition rather than a deadly diagnosis. Keep an eye on these innovations—they could revolutionize your future and redefine what’s possible in cancer care. The truth is, targeted therapies are shaping a new era in medicine.

A Beginner's Guide to Targeted Cancer Treatments and Cancer Immunotherapy
As an affiliate, we earn on qualifying purchases.
As an affiliate, we earn on qualifying purchases.

A Practical Guide to Breast Cancer Treatment
As an affiliate, we earn on qualifying purchases.
As an affiliate, we earn on qualifying purchases.